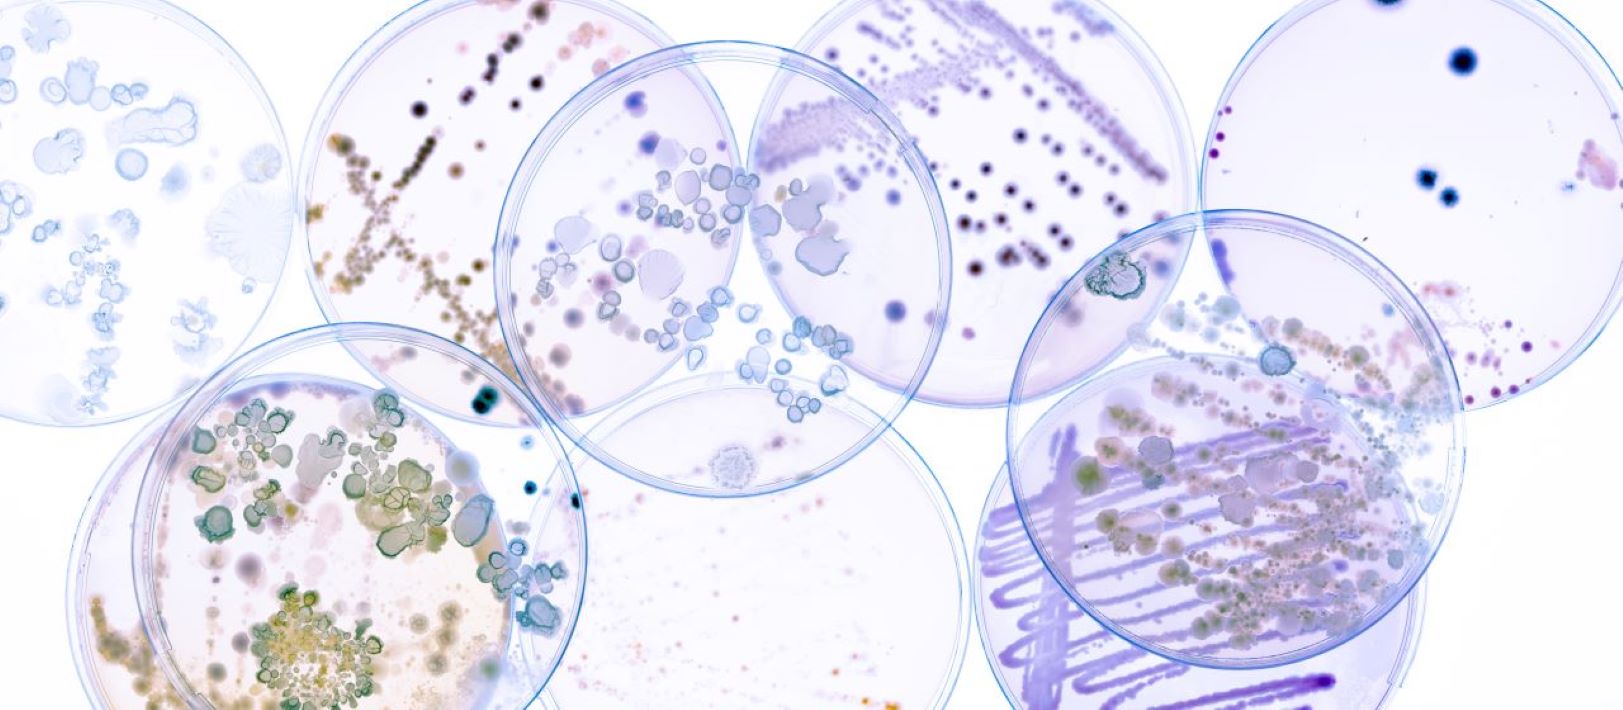
Image of many overlapping Petri dishes

About Us
X-Cell Laboratories of WNY, Inc. (X-Cell) is an independent commercial reference laboratory specializing in anatomic and clinical pathology, hematopathology, and community cancer diagnostics. X-Cell Laboratories of WNY, Inc.provides laboratory services to hospitals, healthcare systems, clinics, and privately-owned medical practices throughout Western New York and beyond.